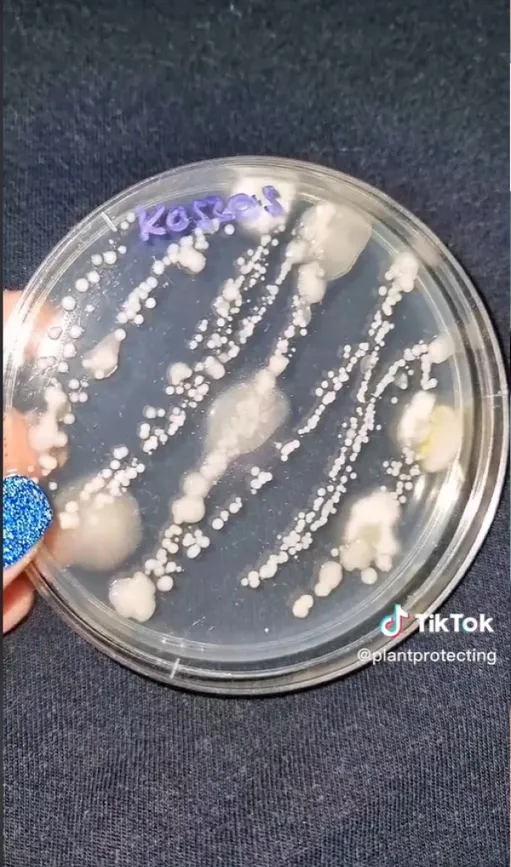
koszos
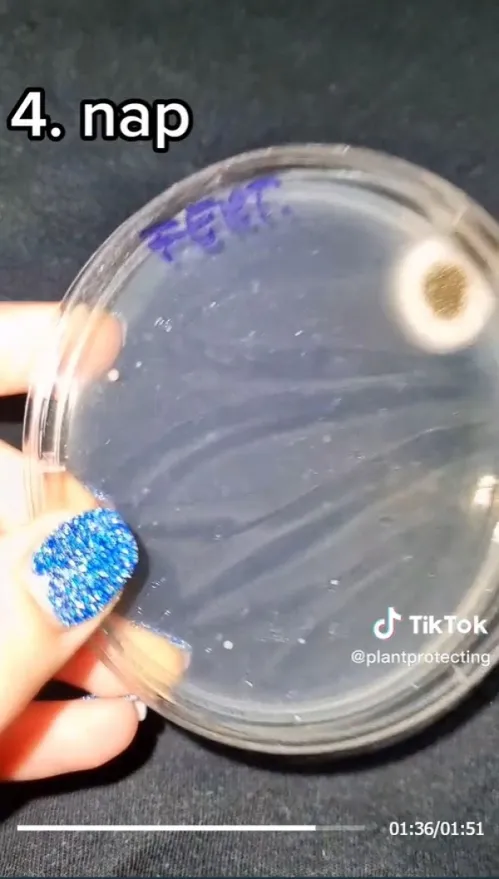
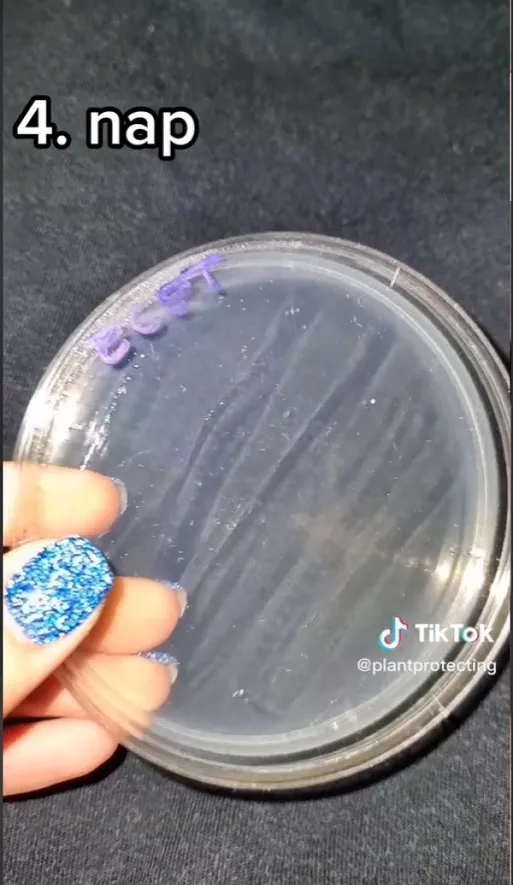

Letesztelte a magyar biológus: akkor a legtisztább a wc-d, ha ezzel takarítod!
Sokakat sokkolt az a TikTokon terjedő videó, amin a wc ülőkéről vett mintából kifejlődött gomba- és baktériumtelepeket mutatja be. A videógyártó remek megoldással is szolgált!
Sokan károsnak tartják a TikTokot, melynek az utóbbi években ugrásszerűen megnőtt a felhasználószáma. A videós közösségi platform tényleg számtalan veszélyes kihívásnak teret ad, de a vicces, táncos és szórakoztató tartalmak mellett rengeteg edukatív és hasznos kisfilmet megtalálunk rajta. Ezek közé tartoznak azok is, melyeket egy magyar orvostanhallgató készít.

Gyuris Rita, növényorvos videóiban elsősorban a lepketartással ismerteti meg követőit, ám emellett számtalan érdekességet és kísérletet is bemutat.
Legnépszerűbb bejegyzései közé tartoznak azok a vizsgálatok, melyekben megnézi, hogy egyes használati tárgyakon mennyi kórokozó található. Az eredmény minden esetben sokkoló volt.
Legújabb videójában Rita a wc deszkát vette górcső alá, illetve arra is választ adott, hogy vajon az ecet, vagy a fertőtlenítő a hatékonyabb a kórokozók ellen.

Különböző mintákat vett: koszos, ecettel tisztított, valamint fertőtlenítővel tisztított felületet is megvizsgálta.
A táptalajon négy napig hagyta felfutni a kórokozókat. Már két nap után megfigyelhető, hogy a koszos esetében a húzott csíkon felnőttek a baktérium kolóniák, míg az ecettel és a fertőtlenítővel tisztított mintán egyelőre semmi ilyesmi nem volt megfigyelhető.
Négy nap elteltével jelentős különbségeket figyelhetünk meg a három minta között.

A kísérlet után elmondható, hogy az ecet vette fel a harcot a leghatékonyabban a kórokozókkal szemben.






